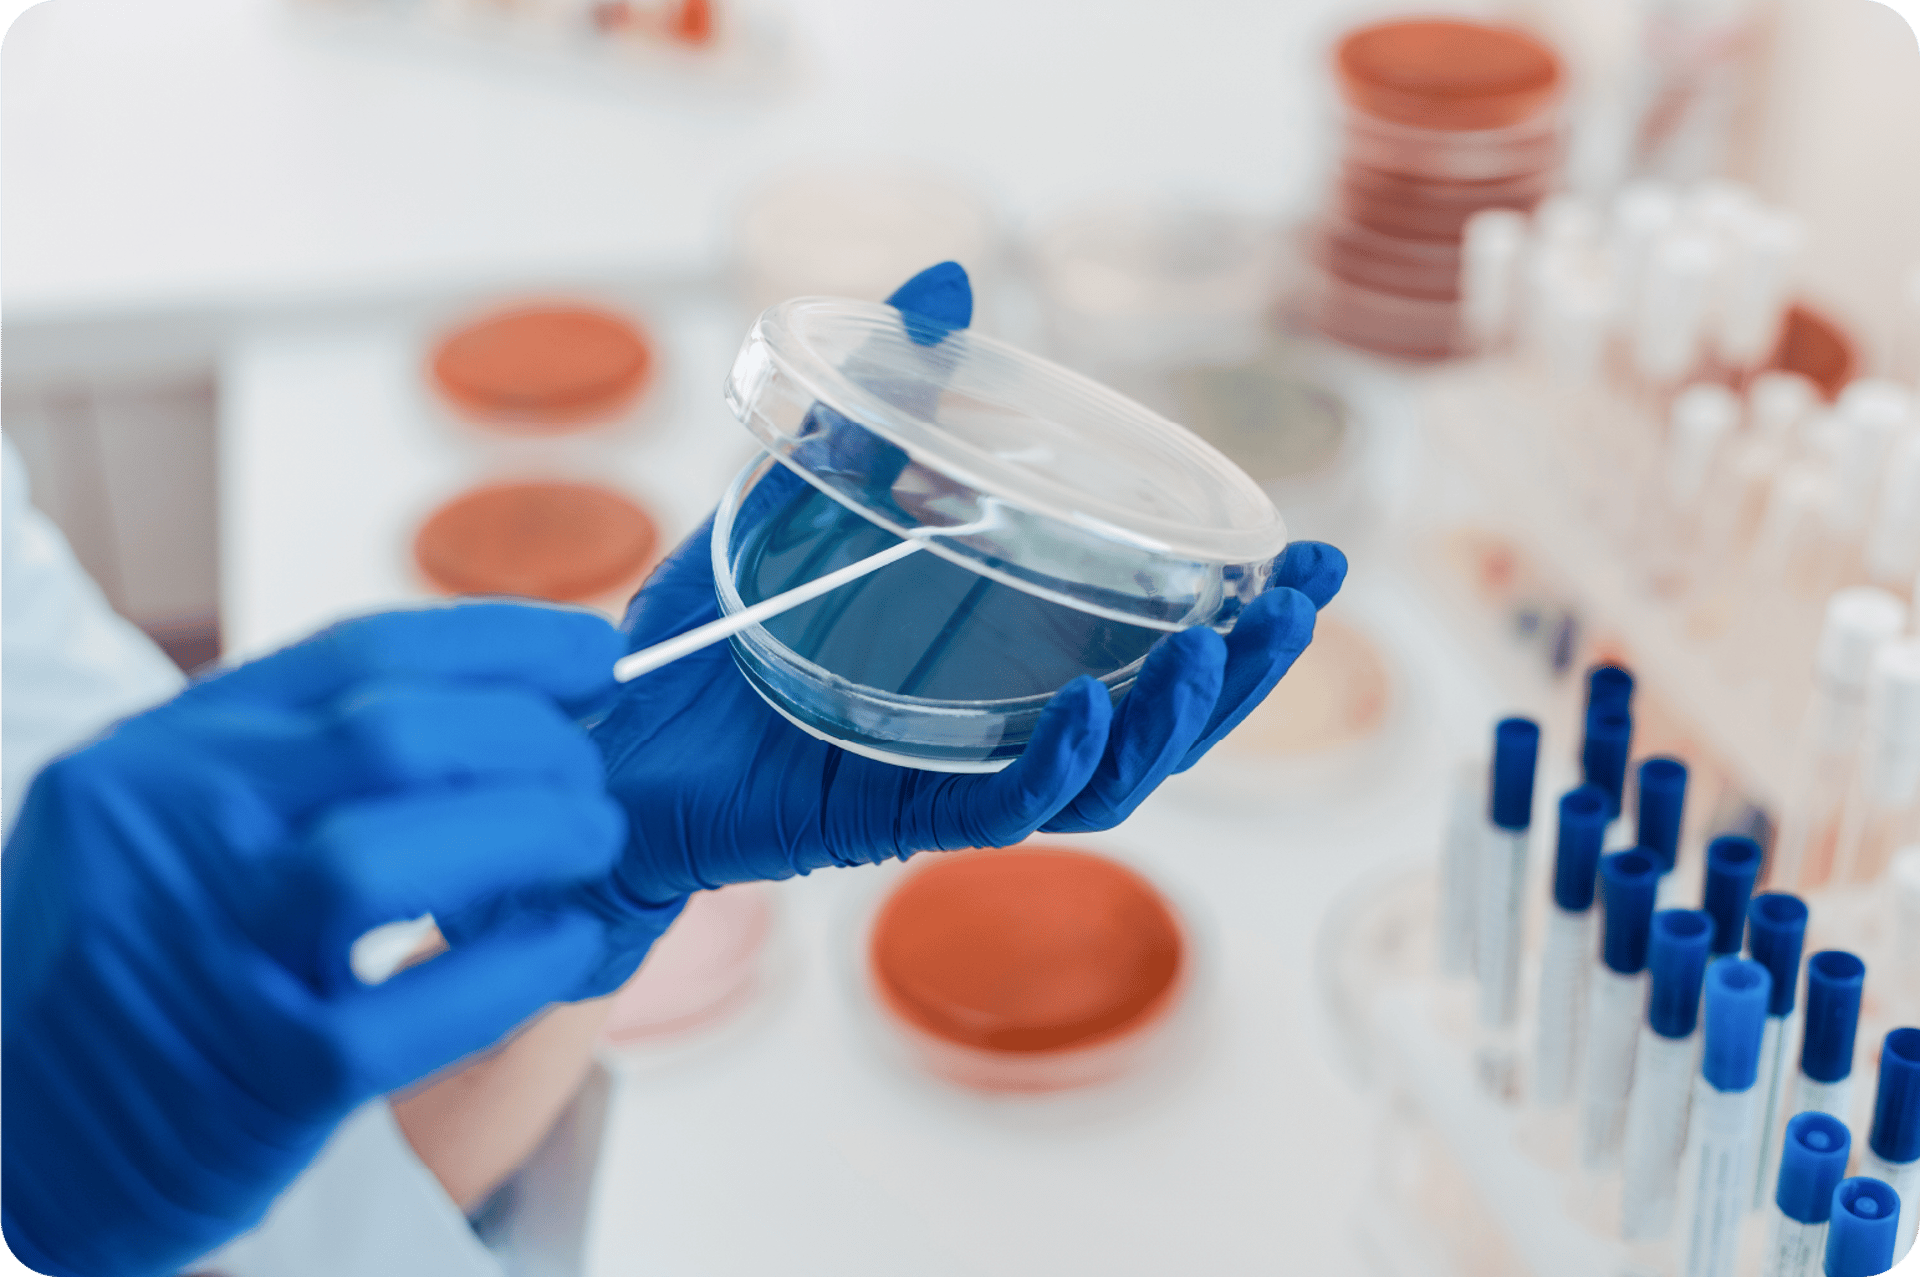
black blue and yellow textile

It's time to feel great
Feel better than you’ve felt in years—without having to rely on willpower.


Scientifically Supported Ingredients
2 Simple Steps
Real Appetite Control
90 Day Money Back GUARANTEE
Try It RISK-FREE!


Featured products
Balance






Unimate
Omegalife-3 Resolv
Bringing you optimal metabolic health
As The Health Intervention Company, Unicity designs and develops innovative nutritional products that make healthy living doable in an on-the-go world.
A journey of discovery
Unicity began as one product, but it has since become a thriving global movement that promotes good health and wellness for millions. While Unicity has grown, our purpose—Make Life Better—has remained the same.


Real solutions for your health
With manufacturing sites and warehouses strategically placed around the world, Unicity is dedicated to creating high-quality products that promote optimal health and wellness for everyone.

Supported by science
Unicity believes in creating innovative products that are based on science. This belief has led to various clinical studies, reputable certifications, US patents, promotions by scientific journals and studies, and more.
Changing lives worldwide








Join our team
The joy of success is even sweeter when you're helping people live their healthiest lives. Share what you love to help us Make Life Better.
Stay Connected
Get tips and updates for better health
UNICITY
8350 Briova Dr, Las Vegas, NV 89113
Online customer support hours
Monday - Friday: 7am - 7pm MT
Weekends: 7am-4pm MT
Contact
Connect
Email:cs@unicity.com
We'll answer as soon as we can, or you can navigate to the Help Center to get help right away.
© 2025 Copyright Unicity International, Inc. All Rights Reserved.